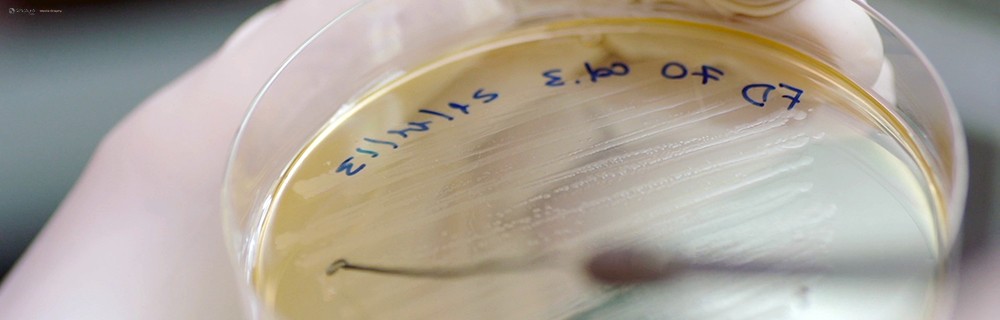

2Picture MediA NEWS

Agriculture and New Frontiers
- Font size: Larger Smaller
- Hits: 3183
- Subscribe to this entry
Last year it was interesting to meet with some of the researcher of the CREA (Viticulture and Oenology Research Center). The Idea came up during a chat with "Edoardo Comiotto" with whom we decided to explore a little more in depth this new, almost magical world of modern agriculture and the forefront of the technologies governing it. So the theme of a new documentary came up and off we went to shoot a promo for potential investors on the project. Unfortunately the Documentary is still work in progress but we are doing our best to keep looking for potential interest from media and financing. So keep an eye on this space.
ITALY AND RESEARCH, IT'S DOWNSIDES AND POTENTIAL.
Even though Italy is at the 5th place in the world when it comes to scientific publications and prestigious researchers it seems there is a sort of "reluctancy" in transforming internationally accredited studies in actual patents. Moreover it appears that young and well trained researchers are finding better shores abroad rather than here in their home country.
There is a wealth of of excellencies available in the various fields of biotech research and technology here in Italy although, at the same time, there is also a lack of financing on the specific sector. These technologies and the research conducted in Italy has great potential and, if applied practically, it could provide a great deal of support in making Agriculture and the whole of the "Agribusiness" much more advanced than it is at its present state.
Research in general would require a legislation that is fresh and in line with modern times and better support from political bodies that should start believing in innovation as the main engine for growth both economical, social and also occupational. New findings in the scientific arena are often perceived as suspicious by the general public that is more easily influenced by social medias or quick and dirty, or at best "sensationalistic" journalism. (as in the case of recent articles about "prosecco wine" in British and Italian newspapers).
We leave you now with this quick "Test-promo" that hopefully will be our small contribution to divulge a better understanding of some aspects of this research and specifically on "Cis-Genetics" (for more info on what it is there is an interesting article here: http://www.genitronsviluppo.com/2009/04/06/cisgenica-la-nuova-frontiera-dell-agroalimentare-genetica-ogm/ unfortunately only in Italian...)
Remember to visit our Facebook page and show some love there with some "likes" too :-) https://www.facebook.com/2picture



